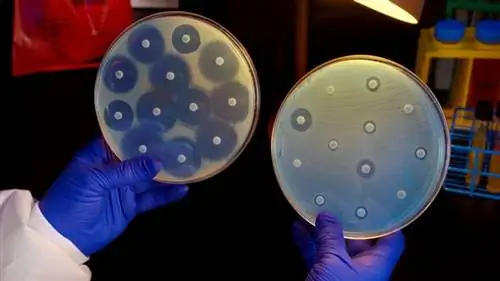
Новое исследование предполагает, что жизнь может распространяться за пределы наблюдаемой Вселенной

Вопрос возникновения жизни является активной областью исследований, сочетающих в себе как астрономию, так и биологию. В частности, вопрос о том, как биохимические составляющие, такие как нуклеотиды, спонтанно собираются в молекулы РНК и ДНК - процесс, называемый абиогенезом, - сбивает исследователей с толку. В этом контексте Томонори Тотани, астрофизик из Токийского университета, рассмотрел вопрос об условиях возникновения жизни во Вселенной.
Работа Тотани, опубликованная в журнале Scientific Reports, основана на нескольких концепциях. Первое связано с возрастом и размером Вселенной, с тем, как она растет со временем, и с вероятностью происходящих событий. Второй - РНК; в частности: какой длины должна быть нуклеотидная последовательность, чтобы «ожидать самореплицирующейся активности», как описано в статье?
В этом исследовании, как и почти во всех работах по абиогенезу, рассматриваются основные компоненты жизни на Земле: РНК или рибонуклеиновая кислота. ДНК устанавливает правила формирования отдельных форм жизни, но ДНК гораздо сложнее РНК. Однако РНК по-прежнему на несколько порядков сложнее, чем необработанные химические вещества и молекулы, найденные в космосе, на поверхности планеты или Луны.
РНК: более вероятно, что она возникнет в результате абиогенеза, чем ДНК
Но его простота по сравнению с ДНК делает его более вероятным в результате абиогенеза. Существует также эволюционная теория, предполагающая, что хотя ДНК несет в себе инструкции по построению организма, именно РНК регулирует транскрипцию последовательностей ДНК. Это называется эволюцией на основе РНК и утверждает, что РНК подвержена дарвиновскому естественному отбору (и также является наследственной).

РНК представляет собой цепочку компонентов, называемых нуклеотидами. Некоторые исследования показывают, что цепочка нуклеотидов должна состоять как минимум из 40-100 нуклеотидов задолго до того, как самовоспроизводящееся поведение, называемое жизнью, сможет существовать. Со временем достаточное количество нуклеотидов может сформировать цепь, чтобы удовлетворить это требование длины. Но вопрос в том, достаточно ли времени прошло с начала Вселенной?
Необходимость рассматривать Вселенную в целом
В своем исследовании Тотани пишет, что текущие оценки предполагают, что число от 40 до 100 нуклеотидов не должно быть возможным в объеме пространства, которое мы считаем наблюдаемой Вселенной. Ключевым здесь является термин «наблюдаемая Вселенная».
“Однако во Вселенной есть нечто большее, чем наблюдаемое. В современной космологии принято считать, что Вселенная пережила период быстрого расширения, создавшего обширную область расширения за горизонтом того, что мы можем непосредственно наблюдать. Учет этого большего объема в моделях абиогенеза значительно увеличивает шансы на появление жизни», - объясняет Тотани.
Согласно статье Тотани, наша Вселенная, вероятно, включает более 10100солнцеподобных звезд, в то время как наблюдаемая Вселенная содержит только около 10 22 звезд. Мы знаем, что жизнь возникла хотя бы один раз, поэтому не исключено, что абиогенез будет воспроизводиться хотя бы один раз, даже если шансы бесконечно малы.
Неизбежное абиогенное появление РНК
Согласно статистике, количество материи в наблюдаемой Вселенной должно быть способно производить РНК только длиной 20 нуклеотидов, что намного меньше числа 40 к 100. Но из-за быстрой инфляции большая часть Вселенная ненаблюдаема. Свет, излучаемый Большим Взрывом, слишком далеко, чтобы достичь нас.

Связано: Ученые говорят, что Мультивселенная может быть полна жизни, но также проблематична
Когда космологи складывают количество звезд в наблюдаемой Вселенной с количеством звезд в ненаблюдаемой Вселенной, получается число 10100звезды похожие на Солнце. Это означает, что задействовано гораздо больше материала, и абиогенное создание достаточно длинных цепочек РНК не только возможно, но вероятно и даже неизбежно.
В своей статье Тотани раскрывает изучаемые фундаментальные отношения. «Здесь выводится количественное соотношение между минимальной длиной РНК в минуту, необходимой для образования первого биологического полимера, и размером Вселенной, необходимым для формирования такой длинной и активной РНК путем добавления случайных мономеров.
Внеземная жизнь: она предполагает другой механизм полимеризации
Чтобы вероятность абиотического создания РНК на землеподобной планете равнялась 1, минимальная длина нуклеотидных цепей должна быть меньше примерно 20 нуклеотидов, что намного больше, чем первоначальный минимум из 40. Но ученые не верят, что РНК длиной всего 20 нуклеотидов могут самореплицироваться, по крайней мере, с нашей точки зрения, как наблюдателей жизни на Земле.
Как говорит Тотани в своей статье, «поэтому, если в будущем будут обнаружены внеземные организмы иного происхождения, чем на Земле, это будет означать, что неизвестный механизм полимеризации нуклеотидов происходит намного быстрее, чем случайные статистические процессы».